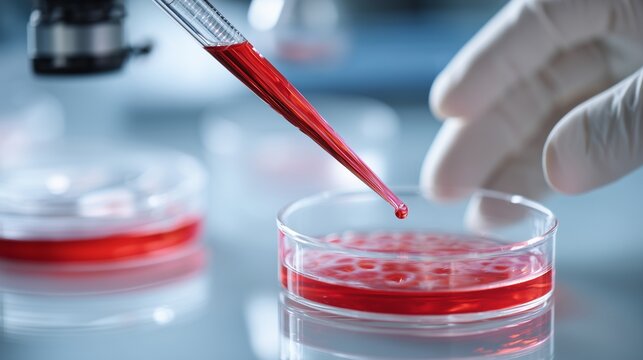
A technician wearing gloves carefully uses a pipette to dispense a red liquid into a petri dish within a laboratory setting. The red liquid is essential for laboratory analysis and

- Home >
- Stock Photos >
- Digital Data Processing Over Laboratory For Modern Medical Advancements
Digital Data Processing Over Laboratory For Modern Medical Advancements Image

This image showcases a modern laboratory setting with digital data overlay of complex algorithms and molecular structures. The presence of biological elements emphasizes ongoing research in global medicine. Ideal for use in articles discussing technological advancements in biomedical sciences or digital transformation in medical research.
2
downloads
downloads
Tags:
More
Credit Photo
If you would like to credit the Photo, here are some ways you can do so
Text Link
photo Link
<span class="text-link">
<span>
<a target="_blank" href=https://pikwizard.com/photo/digital-data-processing-over-laboratory-for-modern-medical-advancements/cba6098d135e6280bb07b7b1ffc92e82/>PikWizard</a>
</span>
</span>
<span class="image-link">
<span
style="margin: 0 0 20px 0; display: inline-block; vertical-align: middle; width: 100%;"
>
<a
target="_blank"
href="https://pikwizard.com/photo/digital-data-processing-over-laboratory-for-modern-medical-advancements/cba6098d135e6280bb07b7b1ffc92e82/"
style="text-decoration: none; font-size: 10px; margin: 0;"
>
<img src="https://pikwizard.com/pw/medium/cba6098d135e6280bb07b7b1ffc92e82.jpg" style="margin: 0; width: 100%;" alt="" />
<p style="font-size: 12px; margin: 0;">PikWizard</p>
</a>
</span>
</span>
Free (free of charge)
Free for personal and commercial use.
Author: People Creations